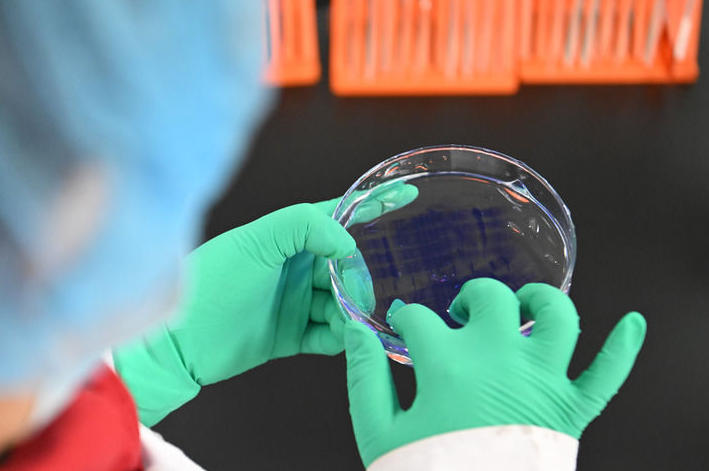

一切伟大成就都是接续奋斗的结果,一切伟大事业都需要在继往开来中推进。
“十四五”即将圆满收官、“十五五”正待开启序幕之际,中央经济工作会议12月10日至11日在北京举行。
习近平总书记在会上发表重要讲话,总结2025年经济工作,分析当前经济形势,部署2026年经济工作,驾驭中国经济航船破浪前行。
锚定“十五五”时期经济社会发展主要目标,确保“十五五”开好局、起好步,以习近平同志为核心的党中央团结带领全党全国各族人民迎难而上、勇往直前,奋力书写中国经济的崭新篇章。
信心与定力:“我国经济顶压前行、向新向优发展”
2025年,中国式现代化进程中具有重要意义的一年。
今年以来,国际环境变乱交织,我国发展经历转型调整的挑战,经济稳定运行压力有所上升。
面对国内外形势深刻复杂的变化,全党全国勠力同心、奋力拼搏,坚定不移贯彻新发展理念、推动高质量发展,经济社会发展主要目标将顺利完成。
“我国经济顶压前行、向新向优发展,展现强大韧性和活力。”10日第一次全体会议上,习近平总书记对今年经济工作作出全面总结。
这是一份难能可贵、成色十足的成绩单——
运行总体平稳,稳中有进,预计全年经济总量将达到140万亿元左右,就业总体稳定,外贸较快增长,出口多元化成效明显;
现代化产业体系建设持续推进,新质生产力稳步发展,科技创新成果丰硕,人工智能、生物医药、机器人等研发应用走在世界前列;
2025年2月20日,在位于京津中关村科技城的中科拜克(天津)生物药业有限公司,实验人员在检验生物制品蛋白分子量。新华社记者 孙凡越 摄
改革开放迈出新步伐,全国统一大市场建设向纵深推进,综合整治“内卷式”竞争成效显现,自主开放有序推进;
重点领域风险化解取得积极进展,地方政府隐性债务有序置换,中小金融机构改革化险成效明显,守住了不发生系统性风险的底线;
民生保障更加有力,育儿补贴、学前一年免费教育等政策相继实施,社会保障水平持续提高,社会大局保持稳定……
2025年2月20日,在山东省日照市东港区知子树托幼园,老师陪伴孩子做游戏。新华社记者 郭绪雷 摄
走过风雨洗礼、劈波斩浪的2025年,更显“十四五”时期我国发展历程的极不寻常、极不平凡。
习近平总书记细数过去5年我国发展的一个个突出亮点:“科技创新成果令世界刮目相看”“越来越多品牌蜚声海外”“APEC蓝成为常态”“平安中国成为靓丽的国家名片”……
“我们有效应对各种冲击挑战,推动党和国家事业取得新的重大成就,第二个百年奋斗目标新征程实现良好开局。”习近平总书记对“十四五”时期发展作出高度评价。
这是信心与共识的凝聚。
10日下午开始,与会同志进行分组讨论,谈认识、讲体会、提建议。
大家一致表示,这些重大成就的取得,根本在于以习近平同志为核心的党中央领航掌舵,在于习近平新时代中国特色社会主义思想特别是习近平经济思想科学指引。
登高望远,拨云见日。
会议着眼全局,从外部环境变化影响加深、国内供强需弱矛盾突出、重点领域风险隐患较多等方面,深入分析我国发展面临的老问题与新挑战。
“这些大多是发展中、转型中的问题,绕不开、躲不过,但经过努力是可以解决的。”习近平总书记坚定指出,总体上看,我国经济长期向好的支撑条件和基本趋势没有改变。我们要坚定信心、用好优势、应对挑战,不断巩固拓展经济稳中向好势头。
清醒的判断,源自对时代脉搏的准确把握。
在以往中央经济工作会议基础上,这次会议进一步总结我们党对经济工作的规律性认识。
习近平总书记以“五个必须”概括做好新形势下经济工作新的认识和体会——
“必须充分挖掘经济潜能”,强调要进一步用好我国产业体系完整、市场规模巨大、人才资源丰富等优势;
“必须坚持政策支持和改革创新并举”,强调既要加大宏观政策逆周期调节力度,又要不失时机深化改革,激发创新活力;
“必须做到既‘放得活’又‘管得好’”,强调“放”的目的是破除影响生产力发展的体制机制障碍,“管”的本质要求是建设法治经济;
“必须坚持投资于物和投资于人紧密结合”,强调既要扩大对实体经济和科技创新的有效投资,又要加强人力资源开发;
“必须以苦练内功来应对外部挑战”,强调面对国际风云变幻和各种风险挑战,要保持战略定力,坚定不移把自己的事情办好。
与会同志认为,“五个必须”是实现高质量发展、推进中国式现代化的科学方法论,进一步丰富和发展了习近平经济思想,为做好经济工作提供了新的重要遵循。
乘风破浪,扬帆远航。
习近平总书记的重要讲话激发起强烈共鸣和强大信心:“力求在扩大消费和投资、发展科技和产业、促进城乡融合和区域协调发展等方面培育形成更多新的增长点”“调动地方和企业积极性,推动经济更多转向内生增长”“不断做强做优做大实体经济,全面增强自主创新能力”。
方向与路径:“稳中求进、提质增效”
2026年是“十五五”开局之年,中国经济航船迎来新的出发。
逐梦未来的新航程,有开阔水域,也有激流险滩——
放眼全球,百年变局加速演进,国际力量对比深刻调整,新一轮科技革命和产业变革加速突破。同时,单边主义、保护主义抬头,国际经贸秩序遇到严峻挑战,大国博弈更趋激烈。
环顾国内,把握发展的重要战略机遇期,我国正坚定不移以高质量发展推进中国式现代化,但发展不平衡不充分问题仍然突出。
变局蕴含机遇,挑战激发斗志。
“完整准确全面贯彻新发展理念,加快构建新发展格局,着力推动高质量发展”;
“更好统筹国内经济工作和国际经贸斗争,更好统筹发展和安全”;
“推动经济实现质的有效提升和量的合理增长,保持社会和谐稳定”;
…………
习近平总书记高瞻远瞩、深谋远虑,为做好开局之年经济工作指明方向。
“稳中求进、提质增效”,这8个字指明2026年经济工作的政策取向。
稳中求进工作总基调,是我们党治国理政的重要原则,是“十五五”时期仍需一以贯之的重要方法论。
统筹“稳”与“进”,要精准施策,增强宏观政策前瞻性针对性协同性。
——继续实施更加积极的财政政策。保持必要的财政赤字、债务总规模和支出总量。
——继续实施适度宽松的货币政策。引导金融机构加力支持扩大内需、科技创新、中小微企业等重点领域。
——增强宏观政策取向一致性和有效性。将各类经济政策和非经济政策、存量政策和增量政策纳入宏观政策取向一致性评估。
会议在宏观政策部署上,以继续实施“更加积极有为的宏观政策”的稳定信号,夯实经济大盘的稳定底座,加快推动经济发展从量到质的转变。
一位与会同志深有感触地说,明年政策取向在“稳”和“进”的基础上,强调“质”和“效”,既释放宏观政策“稳”的信号,又顺应“十五五”开局指明优化方向,彰显复杂变局下党中央对时与势的准确把握。
提升“质”与“效”,要锚定目标,在坚持高质量发展中赢得主动。
在一个更加不稳定不确定的世界中谋求发展,唯有走好自己的路,才能“乱云飞渡仍从容”,在变局中勇开新局。
会议以“八个坚持”部署明年经济工作重点任务,“坚持内需主导,建设强大国内市场”摆在首位。
大国经济,一个重要特征是内部可循环。
扩大内需,不仅是抵御外部冲击、推动我国经济稳中向好的有效途径,更是推动高质量发展、构建新发展格局的战略之举。
2025年8月27日在浙江省湖州市长兴县虹星桥镇宋高村稻香伴日营地内拍摄的咖啡屋。这是宋高村做优全域土地整治后的农文旅新尝试,集餐饮、旅游、农业和文化于一体。新华社记者 徐昱 摄
“深入实施提振消费专项行动,制定实施城乡居民增收计划”“清理消费领域不合理限制措施,释放文旅、赛事、餐饮、康养等服务消费潜力,同时要加强监管、规范秩序”“着眼惠民生增后劲,推动投资止跌回稳,城市更新是投资重要领域”……
习近平总书记作出的一系列重要部署,强调从供需两侧发力,突出在发展中补齐民生短板。
抓住关键,纲举目张。
“十五五”规划建议中,“建设现代化产业体系,巩固壮大实体经济根基”“加快高水平科技自立自强,引领发展新质生产力”位列12项战略任务前两位。
在应对变局中办好自己的事,坚持创新是破局关键。
这次会议上,习近平总书记围绕“坚持创新驱动,加紧培育壮大新动能”作出新的重大部署。
建设具有全球影响力的国际科技创新中心是习近平总书记亲自谋划、部署推动的一项重大战略任务。
这次会议提出,建设北京(京津冀)、上海(长三角)、粤港澳大湾区国际科技创新中心。
2025年4月26日,在安徽省合肥市,观众在第三届中国(安徽)科技创新成果转化交易会上参观一款数据驱动的全流程机器化学家。新华社记者 周牧 摄
“党中央决定,将北京国际科创中心扩围至京津冀,上海国际科创中心扩围至长三角,目的是加快形成我国原始创新的主要策源地,共同打造科技强国建设的战略指引,树立以科技支撑引领中国式现代化的标杆。”习近平总书记阐明其中的深远考量。
这是2025年12月11日拍摄的位于广州市南沙区明珠湾灵山岛尖的大湾区科学会堂(无人机照片)。新华社记者 邓华 摄
事业发展,要在创新;创新之道,唯在得人。
“制定一体推进教育科技人才发展方案”,这一新举措引起不少与会同志的关注。
“教育是基础,科技是关键,人才是根本,三者协同融合发展体现投资于物和投资于人的紧密结合,是高质量发展的迫切需要,也是应对国际竞争的必然要求。”分组讨论中,与会同志形成共识。
战略上更加主动,战术上更加精准。
坚持改革攻坚,增强高质量发展动力活力;坚持对外开放,推动多领域合作共赢;坚持协调发展,促进城乡融合和区域联动;坚持“双碳”引领,推动全面绿色转型;坚持民生为大,努力为人民群众多办实事;坚持守牢底线,积极稳妥化解重点领域风险。
制定全国统一大市场建设条例;深化外商投资促进体制机制改革;加强重点城市群协调联动,深化跨行政区合作;制定能源强国建设规划纲要;实施稳岗扩容提质行动;着力稳定房地产市场……围绕“八个坚持”,会议提出一系列新部署新举措。
与会同志一致认为,这“八个坚持”突出短期经济工作与中长期高质量发展目标相结合,既是对“十四五”时期成功经验的有效总结,也为“十五五”开局之年指明方向,确保中国经济在“稳中求进、提质增效”轨道上行稳致远。
团结与实干:“确保‘十五五’开好局、起好步”
形势越是复杂,越要加强党的领导,形成统一意志。
这次会议明确了党中央关于明年经济工作的思路、任务、政策,在实际工作中落地落实落细至关重要。
习近平总书记指出:“定了就要落实,各级各部门都要有大局观、执行力。”
抓落实,总书记曾多次强调因地制宜。
这次会议上,习近平总书记围绕发展新质生产力、生态环保、农村改厕等,进一步阐明因地制宜的重要性。
“因地制宜,本质就是实事求是。”总书记强调,落实中需要结合实际、因地制宜,但不能自行其是、搞本位主义。
抓落实,要树立和践行正确政绩观。
会议强调,要坚持为人民出政绩、以实干出政绩,自觉按规律办事,完善差异化考核评价体系。
求真务实,担当作为。与会同志表示,要自觉把思想和行动统一到党中央对形势的科学判断上来,按照党中央决策部署和习近平总书记重要讲话要求,增强责任感和使命感,切实提高应对复杂形势、处理复杂问题的能力,确保上下贯通、执行有力。
政策预期稳,经济大盘才能稳。
会议指出,要全面贯彻明年经济工作的总体要求和政策取向,坚持积极务实的目标导向,着力解决存在的困难问题,在质的有效提升上取得更大突破,增强居民和企业的获得感;增强改革与政策的协同效应,推动经济运行和市场预期持续向好。
2025年6月18日,河北省唐山市芦台经济开发区一家采暖设备企业的工人在生产线上工作。新华社记者 杨世尧 摄
经济工作要取得实效,必须把握关键着力点。
会议明确,围绕做强国内大循环,拓展内需增长新空间;围绕发展新质生产力,推动科技创新和产业创新深度融合;围绕激发高质量发展的动力活力,坚定不移深化改革扩大开放;围绕不断增进民生福祉,加大保障和改善民生力度;围绕守牢安全底线,稳妥做好重点领域风险化解。
2025年11月30日,顾客在海南三亚国际免税城购物。新华社记者 郭程 摄
当前,各地区各部门各方面正在按照党的二十届四中全会《建议》,编制国家和地方“十五五”规划及专项规划。
对此,习近平总书记明确要求:“要加强统筹,精简优化交叉重复、缺乏实效的规划编制任务,防止规划过多过滥。所有规划都要实事求是,追求实实在在、没有水分的增长,推动高质量、可持续的发展。”
未来5年,是基本实现社会主义现代化夯实基础、全面发力的关键时期,良好的开局是成功的一半。
击鼓催征,时不我待。
习近平总书记发出有力号召:“全党全社会要更加紧密团结在党中央周围,万众一心、砥砺前行,奋力实现明年经济社会发展目标任务,确保‘十五五’开好局、起好步。”
(编辑 张晖)